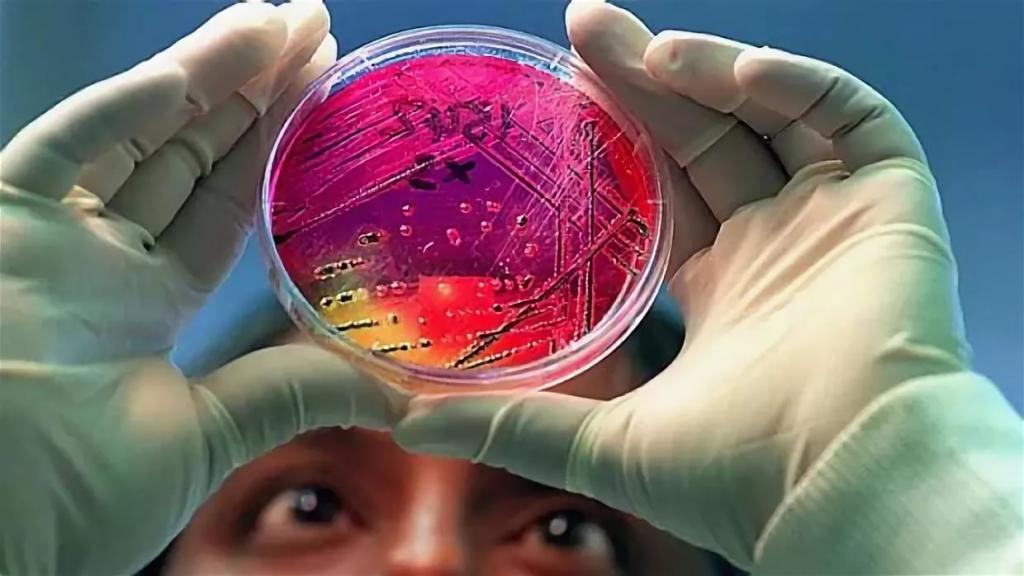
image

Исследование на кишечную группу — это бактериологический анализ, в процессе проведения которого выявляются микроорганизмы, жизнедеятельность которых может привести к развитию инфекционных заболеваний. Биологическим материалом являются каловые массы. Для того чтобы результат исследования был максимально достоверным и информативным, необходимо соблюдать некоторые правила подготовки. Если полученные показатели не соответствуют установленным нормам, врач в индивидуальном порядке составляет схему лечения.
Что позволяет выявить?
Анализ на кишечную группу — это лабораторный вид исследования, с помощью которого можно обнаружить патогенные микроорганизмы, представляющие угрозу для здоровья пациента. Кроме того, врач получает возможность оценить количество полезной микрофлоры.
Анализ на кишечную группу позволяет выявить следующие группы микроорганизмов:
- Условно-патогенные. При нормальном функционировании иммунной системы они безвредны. Когда защитные силы организма ослабляются, запускается процесс их активного размножения, что приводит к развитию всевозможных заболеваний. Примеры микроорганизмов: стафилококк, протей, серафим, клебсиелла, кандида, цито- и энтеробактер.
- Патогенные. Это большая группа бактерий, жизнедеятельность которых представляет угрозу не только для здоровья, но и для жизни человека. В норме их не должно быть в кишечнике. Когда они попадают в организм, запускается процесс их активного размножения. Ткани начинают отравляться токсичными соединениями — продуктами жизнедеятельности бактерий. Подобное состояние является показанием для немедленной госпитализации в стационар. Примеры микроорганизмов: бруцелла, сальмонелла, эшехирии, иерсиния, шигелла, нейссерия.
- Нормальные. Задача полезной микрофлоры — защищать организм от проникновения патогенов, поддерживать и укреплять местный иммунитет, а также ускорять вывод вредных соединений. При воздействии неблагоприятных факторов их функционирование нарушается. Примеры микроорганизмов: лакто- и бифидобактерии, пептококки, бактероиды, клостридии.
Суть метода заключается в том, чтобы поместить флору в искусственно созданную питательную среду. За микроорганизмами наблюдают, затем дифференцируют на виды. Для уточнения результатов бак. анализа на кишечную группу дополнительно проводят биохимические тесты.
Показания
Исследование назначается врачом на основании жалоб пациента и данных анамнеза. Показания к проведению анализа на кишечную группу:
- Длительные нарушения в работе органов желудочно-кишечного тракта.
- Частые эпизоды запоров.
- Длительное лечение антибиотиками.
- Наличие выраженной аллергической реакции, не отступающей на фоне терапии.
Кроме того, необходим анализ кала на кишечную группу для госпитализации. Также исследование проводится у лиц в период реабилитации после выздоровления.
Подготовка
Для того чтобы результаты анализа на кишечную группу были достоверными, необходимо некоторое время до сдачи биоматериала следовать врачебным рекомендациям.
Подготовка к исследованию подразумевает выполнение определенных действий:
- За 7 дней нужно отменить прием слабительных препаратов и антибиотиков. На фоне лечения данными медикаментами микрофлора кишечника нарушается. Результаты анализа в подобной ситуации будут неверными. Если отмена препаратов невозможна по жизненным показаниям, необходимо поставить об этом в известность лечащего врача.
- За 5 дней нужно внести корректировки в рацион питания. Из меню необходимо исключить продукты, употребление которых может спровоцировать процесс брожения. К ним относятся: ягоды, фрукты, овощи, стручковая фасоль, свежее молоко. Также необходимо отказаться от употребления спиртосодержащих напитков.
- За 7 дней нужно перестать вводить в прямую кишку ректальные свечи.
Данные правила подготовки к анализу на патогенную кишечную группу актуальны в отношении как взрослых, так и детей.
Забор биоматериала
Первоначально необходимо выбрать тару. Она должна быть стерильной и плотно закрывающейся. Одноразовый контейнер для кала можно приобрести в любой аптеке. Изделие реализуется вместе с ложечкой, благодаря чему сбор биоматериала становится удобнее. В качестве альтернативы можно использовать стеклянную баночку маленькой емкости с плотно завинчивающейся крышкой. Но предварительно ее нужно тщательно помыть и прокипятить.
Относительно того, как сдавать анализ на кишечную группу, алгоритм действий будет таким:
- В утренние часы совершить акт дефекации. Позывы должны быть естественными, недопустимо предварительно ставить очистительную клизму.
- Забор биологического материала должен быть произведен с чистой поверхности. Игнорирование данной рекомендации приводит к обсеменению каловых масс посторонними бактериями.
- Брать кал желательно из средней части полученного биологического материала. Если в массах визуализируются прожилки крови или гной, их также необходимо поместить в контейнер или баночку.
- Масса фекалий не должна быть меньше 20 г. Это примерно 3 мерные ложечки, которые продаются вместе с контейнерами.
- Плотно закрыть емкость и подписать ее.
- Отнести контейнер или баночку с биоматериалом в лабораторию.
Кал не рекомендуется хранить. Его желательно сразу доставить в лабораторию. Если такой возможности нет, допускается поместить биоматериал в холодильник. Но и там он может находиться не более 4 часов.
Интерпретация результатов
Через 4-6 рабочих дней (в государственных поликлиниках процесс может затянуться до 2 недель) пациенту выдается справка. Анализ на кишечную группу должен расшифровывать врач, однако можно и самостоятельно интерпретировать результаты.
Показатели нормы для взрослых и детей старше 1 года (выраженные в КОЭ):
- Бифидобактерии — не менее 1*10 9 .
- Лактобактерии — 1*10 7 .
- Кишечная палочка — 1-7*10 8 .
- Кокки (от общего числа микроорганизмов) — до 25%.
- Лактозоотрицательные энтеробактер — до 5%.
Патогенной флоры в биоматериале быть не должно. При ее обнаружении врач назначает соответствующее лечение.
Схема терапии
Проблема требует комплексного подхода. Схема лечения составляется на основании результатов анализа на кишечную группу.
Общие принципы лечения при обнаружении большого количества условно-патогенных микроорганизмов:
- Прием антибиотиков. Медикаменты из данной группы назначаются только при выявлении возбудителя. Дополнительно проводится тест на чувствительность бактерий к антибиотикам.
- Прием пребиотиков. Необходим для заселения кишечника бифидо- и лактобактериями.
- Прием пробиотиков. Данные препараты содержат живые формы полезной микрофлоры.
- Прием или введение иммуномодуляторов. Активные компоненты данных препаратов способствуют укреплению защитных сил организма.
При обнаружении в биоматериале патогенной флоры показана госпитализация пациента в стационар. Кроме того, лицам, контактировавшим с больным, также необходимо пройти обследование.
Где сдать?
Забор биологического материала осуществляется как в частных, так и государственных медицинских учреждениях. В последнем случае необходимо предварительно оформить направление на исследование у терапевта.
Стоимость
Цена исследования напрямую зависит от региона проживания, а также от уровня и политики медицинского учреждения. В независимых лабораториях стоимость анализа составляет в среднем 800 рублей.
Исследование на кишечную группу в государственных поликлиниках осуществляется на бесплатной основе. Достаточно лишь при оформлении направления предьявить медицинский страховой полис.
В заключение
Кишечник человека заселен несколькими сотнями микроорганизмов. Полезные бактерии выполняют защитную функцию и способствуют скорейшему выведению из тканей токсичных соединений. Условно-патогенная флора в норме тоже должна находиться в кишечнике, но в небольшом количестве. Жизнедеятельность данных микроорганизмов представляет опасность только при стремительном их размножении. Патогенов же в организме не должно быть вообще.
Анализ на кишечную группу позволяет оценить количество тех или иных бактерий. Если превалирует условно-патогенная флора, врач назначает лечение. Терапия проводится амбулаторно. При выявлении патогенов пациента госпитализируют в стационар. Кроме того, обследованию подлежат все лица, контактировавшие с больным в последнее время.
Анализ кала на кишечную группу – это один из методов лабораторного определения острых и хронических заболеваний пищеварительной системы инфекционного генеза (происхождения).
В ходе исследования оценивается соотношение бактериальных групп, составляющих основу микрофлоры кишечника, и возможное присутствие болезнетворных микроорганизмов. Полученные результаты являются основанием для постановки диагноза, выбора тактики терапии и медикаментов.
Нарушение микрофлоры кишечника
Основная часть микросреды сосредоточена в толстой кишке – нижней зоне кишечного отдела пищеварительного тракта. Микрофлору представляют несколько сотен микроорганизмов, образующих симбиотическую систему. Бактерии классифицируются на три кишечных группы: полезные, условно-патогенные и вредоносные (патогенные).
В здоровом кишечнике содержатся только представители первых двух групп, в строго сбалансированном количестве. Их соотношение составляет 9 к 1. Нарушение равновесия между полезными и условно-патогенными бактериями вызывает дисбактериоз (иначе, дисбиоз).
Патогенных микроорганизмов в микрофлоре кишечника быть не должно. При их внедрении в организм, развиваются инфекционные процессы различной степени тяжести. Проникновение патогенов может спровоцировать состояние тяжелой интоксикации, угрожающее жизни пациента. Анализ кала определяет качественно-количественный состав каждой кишечной группы.
| Классификация | Форма существования | Норма в % | Представители |
| группа полезных бактерий | облигатные анаэробы (бескислородное существование) | 90 | бифидобактерии, бактероиды, лактобактерии, энтерококки, кишечная палочка, эубактерии и др. |
| группа условных патогенов | факультативные или не строгие анаэробы (способные к жизни при кислороде и без него) | 10 | стафилококки (сапрофитный, эпидермальный), дрожжевые грибки (кандида), пептококки, фузобактерии, бацилы, клостридии и др. |
| болезнетворные микроорганизмы | факультативные анаэробы и аэробы (нуждающиеся в кислороде) | синегнойная палочка, сальмонелла; холерный вибрион, инвазивная и токсигенная кишечная палочка, шигелла и др. |
Заражение болезнетворными бактериями чаще всего происходит при употреблении инфицированных продуктов, несоблюдении санитарно-гигиенических норм либо вследствие распространения нозокомиальных (внутрибольничных) инфекций.
Показания для проведения исследования
Исследование экскрементов на кишечную группу назначается по совокупности характерных симптомов:
- субфебрильная (37–38°С) и фебрильная (38–39°С) температура тела на фоне многократной диареи и рвоты;
- диспептический синдром (нарушение пищеварения) и боли в области живота;
- наличие в каловых массах кровянистых, гнойных и слизистых примесей;
- слабость, цефалгический синдром (головная боль), бледность кожи, потеря аппетита.
В рамках профилактического обследования анализ кала на кишечные инфекции производится:
- при поступлении ребенка в дошкольное воспитательное учреждение и школу;
- на плановом профосмотре медицинского персонала, работников сферы общественного питания и торговли продовольственными товарами, педагогического состава детских садов;
- после контакта с зараженными людьми;
- во время введения карантина при вспышках кишечных инфекций в детских учебных и дошкольных учреждениях.
В обязательном порядке контрольный анализ каловых масс проводится после курсового лечения кишечной инфекции. В государственных больницах (поликлиниках) направление на проверку микрофлоры выдает врач-инфекционист. Самостоятельно сдать кал на анализ можно на платной основе в лабораторных службах и клинико-диагностических центрах, работающих в Москве и других крупных городах.
Подготовка к анализу
Достоверные результаты исследования обеспечивает правильная подготовка организма, включающая:
- Отказ от применения лекарственных препаратов, которые могут ликвидировать часть микрофлоры кишечника, и тем самым исказить итоговые данные. К таким препаратам относятся антибиотики, сорбенты (Энтеросгель, Полисорб, Активированный уголь и т. д.), закрепляющие и слабительные медикаменты.
- Коррекцию рациона. За 2–3 дня до сдачи экскрементов необходимо устранить из меню жирную пищу, жареные блюда, продукты и напитки, вызывающие излишнее газообразование (фасоль и горох, газировку, капусту, черный хлеб и сдобную выпечку).
- Исключение любых алкоголь содержащих напитков.
- Отказ от использования микроклизм и ректальных суппозиториев.
Назначенное ранее рентгенографическое обследование органов ЖКТ (желудочно-кишечного тракта) необходимо перенести на постаналитический период. При необходимости проведения исследование грудному ребенку, за 3–4 дня до сбора каловых масс запрещается вводить новый прикорм.
Сбор биоматериала на анализ
Для сбора и транспортировки экскрементов в лабораторию необходимо приобрести стерильный аптечный контейнер, снабженный герметичной крышкой и пластиковой ложкой. При жидких каловых массах используется заранее купленная пипетка.
Большинство лабораторий не принимает образцы биоматериала в непредназначенной для этого таре. Попадание в кал посторонних примесей приводит к неточностям в результатах. Сдавать анализ в лабораторию следует утром, не позднее, чем через 2–3 часа после помещения экскрементов в контейнер. Если образцы подвергаются заморозке или хранятся при комнатной температуре более трех часов, они становятся непригодными для изучения.
Сбор частиц кала включает соблюдение следующих условий:
- проведение гигиенических процедур аноректальной области перед опорожнением кишечника;
- опорожнение мочевого пузыря;
- использование судна либо полиэтилена, бумажных листов (непосредственно из унитаза собирать экскременты нельзя, во избежание попадания микробов);
- заполнение контейнера (с помощью ложечки) на одну треть;
- герметичное закрытие емкости.
Если в каловых массах имеются кровяные вкрапления, гнойные примеси, слизь, их фрагменты необходимо собирать в первую очередь. При проведении микроскопии такие примеси могут стать основанием для дальнейшего обследования пациента на онкологию (колоректальный рак), желудочные кровотечения, патологии поджелудочной железы.
Женщинам не рекомендуется сдавать анализ в начале фолликулярной фазы менструального цикла (период кровяных выделений). При экстренной диагностике нужно воспользоваться тампоном, чтобы предотвратить попадание менструальной крови в экскременты.
Забор образца для анализа на кишечную группу может быть произведен в лечебном учреждении. Медицинский специалист вводит в анус пациента стерильный тампон и прокручивает. После извлечения тампон помещается в специальную лабораторную посуду. При хронической диарее забор каловых масс производится посредством катетера.
Проведение исследования
Для изучения сданного биоматериала на кишечную группу используется несколько лабораторных методов. Выбор зависит от предполагаемого диагноза. Бактериоскопия оценивает микрофлору посредством многократного увеличения исследуемого образца под микроскопом. Результатом может быть наличие либо отсутствие патогенных микроорганизмов.
В ходе бактериологического исследования образцы биоматериала помещаются в разные лабораторные емкости со специальными растворами. Жидкости представляет собой питательную среду, благоприятную для развития той, или иной разновидности бактерий.
Присутствие и вид патогенов определяется по их активному росту, размножению, и образованию колоний. Величиной измерения принята КОЕ (колониеобразующая единица). На искусственно выращенной колонии проводится антибиотикограмма (проверка резистентности микроорганизмов к антибактериальным препаратам).
Многие из условно-патогенных и болезнетворных микроорганизмов обладают высокой устойчивостью к антибиотикам. Ценность антибиотикограммы заключается в возможности выбора максимально эффективного препарата для лечения дисбактериоза или кишечной инфекции.
Сколько делается анализ, зависит от активности роста численности бактерий, и степени загруженности конкретной лаборатории. Сроки выполнения могут варьироваться от 3–4 дней до 1,5–2 недель.
Результаты исследований
Для оценки условно-патогенной флоры (УПФ) полученные результаты сравниваются с принятыми нормативами.
| Стафилококки (сапрофитный, эпидермальный) | Грибки рода Кандида | Пептококки | Фузобактерии | Бациллы | Клостридии |
| ≤10 4 | ≤10 4 | 10 9 –10 10 | 10 8 –10 9 | 10 9 –10 10 | ≤10 4 |
Превышение нормы УПФ свидетельствует о развитии дисбактериоза.
| Бифидобактерии | Бактероиды | Лактобактерии | Кишечная палочка | Энтерококки | Эубактерии |
| 10 9 –10 10 | 10 9 –10 10 | 10 7 –10 8 | 10 7 –10 8 | 10 5 –10 8 | 10 9 –10 10 |
При анализе каловых масс на кишечную палочку учитывается разновидность штамма. Вид E. Coli O157:H7 является патогеном и вызывает бактериальные инфекции желчновыводящих и мочевыводящих протоков, а также пневмонию и менингит бактериального характера. В ходе бактериоскопии могут быть обнаружены протозоозы и яйца гельминтов (глистов). В данном случае пациенту назначается дополнительные анализы на выявление паразитарных инвазий.
При определении патогенных микроорганизмов диагноз ставится на основании вида обнаруженных бактерий.
| Название патогена | Заболевание | Особенности бактерии |
| шигелла (Shigella) | шигеллез (бактериальная дизентерия) | высокая вирулентность и токсичность |
| сальмонелла (Salmonella) | сальмонеллез | устойчивость к окружающей среде. Разновидность Salmonella typhi вызывает брюшной тиф. |
| холерный вибрион (Vibrio cholerae) | холера | провоцирует развитие сопутствующих гнойных инфекций |
| синегнойная палочка (Pseudomonas aeruginosa) | инфекционный энтероколит или гастроэнтероколит, синегнойная инфекция органов дыхания, нервной системы, ЖКТ, мочевыводящих путей | высокая подвижность, токсичность иммуностойкость к антибиотикам |
В силу высокой контагиозности кишечных инфекций пациентам с диагностированными заболеваниями показана обязательная госпитализация.
Итоги
Анализ каловых масс на кишечную группу позволяет оценить состояние микрофлоры, диагностировать дисбиоз, дифференцировать вид возбудителя кишечных инфекций и подобрать наиболее результативную терапию.
Многие инфекционные заболевания вызывают тяжелые осложнения, опасные для жизни пациента. Необходимость проведения исследования определяется врачом-инфекционистом. Сдать анализ можно в государственных медицинских учреждениях и платных клинико-диагностических центрах.
Анализ на кишечную группу — популярное исследование. Его назначают как для диагностики острых заболеваний, так и с целью выявления скрытого течения у носителей болезни. Когда у взрослого человека или ребенка появляется понос, температура, боли в животе, рвота, то поставить диагноз только на основании клиники невозможно, поскольку многие кишечные инфекции протекают с похожими симптомами.
Кроме того, для назначения оптимального противобактериального лечения необходимо знать конкретный возбудитель заболевания. Согласно существующим инструкциям санитарной службы и Министерства здравоохранения, все люди, работающие на производстве пищевых продуктов или контактирующие с ними при транспортировке, продаже, упаковке, приготовлении пищи, уборке помещения, регулярно проходят анализ на кишечную группу.
В кишечнике здорового человека спокойно проживают около 500 видов микроорганизмов. Они вполне успешно соседствуют с макроорганизмом, помогают ему выполнять ряд важных функций, сами питаются из кишечного содержимого. Принято разделять по принципу опасности всю флору на 3 вида.
Полезные — в любых условиях поддерживают пищеварение, вырабатывают витамины, обеспечивают иммунитет. Среди них основные:
- бифидобактерии;
- бактероиды;
- лактобактерии;
- эшерихии;
- грибы.
Всего таких микроорганизмов 15. Условно патогенные микроорганизмы безвредны, если человек силен и здоров, но в случае падения защитных сил становятся дополнительным агрессивным фактором и способны нанести существенный вред.
- стафилококки;
- энтерококки;
- кишечная палочка;
- клостридии;
- грибы рода Кандида.
Патогенные — это возбудители инфекционного заболевания, которых в норме не должно быть, но они могут принимать настолько хорошо защищенные формы, что длительно живут в кишечнике носителя в виде цист. А человек даже не подозревает, что является разносчиком инфекции. К ним относятся:
- сальмонелла;
- шигелла;
- дизентерийная амеба;
- кишечная трихомонада;
- балантидий;
- холерный вибрион и другие.
Если врач назначает анализ кала на кишечную группу, то его в первую очередь интересуют вероятные возбудители болезни. Ведь зная их особенности и поражающие свойства можно:
- выяснить источник заражения;
- ограничить распространение очага заболевания;
- обследовать контактных лиц;
- назначить курс оптимальной терапии.
Какие патогенные микроорганизмы выявляются наиболее часто?
Пациент с острым расстройством пищеварения и подозрением на заражение направляется в инфекционное отделение стационарного типа. Дети госпитализируются вместе с мамами. В условиях больницы удается изолировать больного, провести максимально полное обследование и лечение.
Наиболее часто кишечная группа возбудителей проявляется следующими заболеваниями:
Эти примеры показывают насколько важно своевременно проводить анализ не только кала, но и продуктов питания, питьевой воды, смывов с рук персонала. Особенно если болезнь выявлена в детских учреждениях.
Как сдавать анализ?
Для получения достоверных результатов пациента предварительно следует подготовить:
- рекомендуется 4–5 дней не есть мясных блюд, не принимать алкоголь, питаться только молочными продуктами, кашами, картошкой, белым хлебом;
- за три дня до сбора кала прекратить прием антибиотиков, слабительных средств, препаратов железа (заранее можно предположить отрицательный результат у пациентов, которые самостоятельно начали лечение антибиотиками), введение ректальных свечей.
К правилам сбора относятся:
- предупреждение попадания в исследуемый материал посторонних примесей (мочи, крови при менструации у женщин), ребенку нужно дать возможность предварительно помочиться, женщинам применять чистый влагалищный тампон, если нельзя перенести срок анализа;
- посуду для исследуемого материала нельзя обрабатывать дезинфицирующими средствами (хлоркой), баночку нужно хорошо промыть с мылом и облить кипятком;
- таким же образом обрабатывается горшок малыша;
- на доставку в лабораторию отводится не более двух часов, хранение в холодильнике допускает 4 часа отсрочки, чем дольше задержка срока транспортировки, тем менее результативными будут полученные данные, поскольку часть возбудителей погибает.
Забор анализа проводится:
- в домашних условиях — в стерильную посуду, по объему следует ориентироваться приблизительно на полную чайную ложку;
- в инфекционном кабинете или в стационаре берут ректальный мазок тампоном, в положении пациента на боку лаборант вводит стерильный тампон на палочке в прямую кишку на небольшую глубину и проворачивает его, затем сразу помещает в пробирку со специальной средой;
- у маленького ребенка можно взять материал непосредственно с памперса.
Как проводится исследование?
Собранный материал в небольшом количестве помещают на 4–5 дней на питательную среду. Здесь вырастают колонии, из которых можно приготовить мазок на кишечную группу даже при очень малом количестве микроорганизмов.
Квалифицированные бактериологи способны выявить патологические возбудители, ориентируясь на внешний вид, подвижность под микроскопом. Метод называется бактериоскопией.
- 18 Октября, 2019
- Анализы и диагностика
- Вера Васильева
Одни из важнейших методов при проведении медицинского обследования — это лабораторные исследования. Зачастую эти данные играют решающую роль при постановке диагноза. Кал — это выделяемое при дефекации из дистального окончания кишечника. В норме кал состоит приблизительно на 80% из воды, а 20% — это остатки жизнедеятельности, непереваренных частей пищи и микроорганизмов.
Микробиом кишечника
Известно, что в кишечнике человека содержится около 500 видов различных микробов. Их разделяют на три группы:
- Полезные. К ним относятся бактероиды, бифидобактерии, лактобактерии и другие.
- Условно-патогенные. При хорошем иммунитете и отсутствии патологий ЖКТ их наличие никак не проявляется. Однако, при ухудшении здоровья и различных негативных факторах, они могут причинить значительный урон организму. Это – клостридии, стафилококки, энтерококки, грибки Кандида, кишечная палочка и другие.
- Патогенные. Это возбудители множества инфекционных заболеваний, которые в норме у человека должны отсутствовать. К ним относятся: амеба дизентерийная, сальмонелла, трихомонада кишечника, холерный вибрион, балантидий и другие.
Что входит в анализ кала на кишечную группу и какие микроорганизмы выявляются наиболее часто?
Среди наиболее выявляемых бактерий можно выделить следующие:
- Бактерии дизентерийной группы, вызывающие шигеллез (дизентерию) – протекающее в острой форме инфекционное заболевание, имеющее фекально-оральный способ заражения. Поражает толстую кишку, проявляется такими симптомами, как диарея, боли в животе, повышение температуры, кровь и гной в кале.
- Не менее опасными являются бактерии тифо-паратифозной группы. К ним относят возбудитель брюшного тифа — Salmonella typhi и возбудитель паратифов — Salmonella paratyphi A, B, C, а также возбудители других сальмонеллезов. Возбудитель передаются фекально-орально, поражает по большей части желудочно-кишечный тракт. Наблюдаемые симптомы: рвота, тошнота, спазмы, нарушение стула, повышение температуры. При брюшном тифе может наблюдаться поражение ЦНС в виде заторможенности и нарушения сознания.
- Патогенные кишечные палочки являются причиной эшерихиозов – острых инфекционный кишечных заболеваний, которым в основном подвержены дети. Среди патогенных кишечных палочек выделяют приводящих к холероподобной диарее, вызывающие диарею главным образом у детей, приводящие к дизентериеподобной диарее и наличию крови в кале.
Определить наличие болезнетворных микроорганизмов и их чувствительность к антибактериальной терапии можно с помощью такого метода микробиологии, как культивирование на питательных средах.
Показания к сдаче анализа
Основной причиной для сдачи посева кала на кишечную группу является подозрение на присутствие в кишечнике патогенных или условно-патогенных микроорганизмов в активной форме. Кроме этого, анализ назначают во время плановых проверок и при поиске скрытых бессимптомных инфекций при прохождении различных медкомиссий, в том числе, для получения санитарной книжки лицами с большим риском быть распространителями кишечных заболеваний (к примеру, сотрудники сферы общественного питания). При выявление патологических процессов большую роль играет анализ кала на кишечную группу. В случае обнаружения вредоносных микроорганизмов определяется их чувствительность к антибиотикам, а врачам анализ дает возможность осуществить эффективное лечение. Анализ на кишечную группу, что это такое? Данный анализ — важнейшая часть лабораторного исследования фекалий. Анализ кала способствует выявлению разнообразных патологических процессы, протекающих в организме. Анализ кала на кишечную группу дает возможность отслеживать эффективность проводимого лечения. Кроме того, анализ кала играет решающее значение при обследовании на наличие паразитов (гельминты, лямблии и другие).
Как сдавать кал на кишечную группу?
Перед осуществлением забора биоматериала для анализа необходимо провести соответствующую подготовку. Важные моменты при подготовке к сдаче анализа:
- Питание. За 3-5 суток до анализа исключить пищу, содержащую рыбу и мясо в любом виде. Кроме того, перед тем как сдавать анализ кала на кишечную группу следует воздержаться от употребления алкоголя. Также из рациона питания стоит исключить мучные и хлебобулочные изделия, продукцию из молока, а также картофель и блюда на его основе. Также будет не лишним существенно ограничить употребление различных соусов, маринадов и блюд, содержащих бобовые культуры, грибы, зеленые овощи, помидоры, фрукты.
- Медицинские препараты. За трое суток до проведения процедуры забора анализа на кишечную группу следует перестать принимать лекарства, способные оказывать существенное влияние на характеристики кала. К подобным средствам относятся антибактериальные препараты, медикаменты, влияющие на перистальтику (слабительные средства), а также препараты, содержащие железо и висмут. Кроме того, из средств местного применения следует исключить ректальные суппозитории (свечи).
- Привычки. При проведении анализа фекалий на кишечную группу не обязательны ограничения относительно курения. Помимо этого, сам забор материала может быть осуществлен не натощак, следовательно, можно придерживаться обычного суточного рациона питания и питьевого режима с учетом перечисленных выше ограничений.
Забор кала на анализ на кишечную группу может проводиться как в больничном учреждении, так и в домашних условиях. При сдаче анализа в медицинском учреждении пациент приходит в отделение, где укладывается на кушетку и поворачивается на бок. Лаборант осуществляет стандартный мазок, применяя обычный стерильный тампон, вводимый в прямую кишку пациента на несколько сантиметров, в то же время прокручивая его с целью лучшего сбора биологического материала. Далее тампон должен быть извлечен и помещен в специальную пробирку с подготовленной средой. Затем биоматериал подвергается анализу в соответствии с существующими протоколами. Для того чтобы собрать фекалии на анализ кишечной группы в домашних условиях, необходимо приобрести в аптеке стерильный, герметично закрывающийся контейнер с крышкой. В случае, когда кал требуется собрать у маленького ребенка, использующего одноразовые подгузники, необходимые фекалии разрешается брать непосредственно с них сразу же после опорожнения кишечника (слой биоматериала, который не соприкасался с абсорбирующей поверхностью подгузников).
Правила сбора кала для анализа
Фекалии, требуемые для анализа, собираются утром во время первого акта опорожнения кишечника. Перед проведением процедуры необходимо тщательно вымыть унитаз, особенно его внутреннюю поверхность без применения средств дезинфекции, например, водой и специальным ершиком. После дефекации следует собрать каловую массу специальной мерной ложкой из стерилизованного контейнера для сбора экскрементов, которая зачастую идет в комплекте с контейнером, либо ее можно приобрести дополнительно в любой аптеке. В фекалии не должны попасть дополнительные примеси, такие как моча или кровь (во время менструации у женщин).
Собранный данным методом биологический материал следует незамедлительно отнести в лабораторию для проведения анализа кала на кишечную группу.
Сколько времени может храниться биоматериал?
Согласно рекомендации профильных специалистов, доставить собранные каловые массы следует не позже двух часов для проведения наиболее достоверного анализа на кишечную группу. При отсутствии возможности транспортировать собранный биологический материал в указанный срок, стерильный и герметично закрытый контейнер можно поместить в холодильник, с целью увеличения указанного временного интервала, но не более чем на четыре часа. Если же после сбора каловых масс прошло уже больше шести часов, то точность анализа на кишечную группу значительно снижается, возможен ложноположительный или ложноотрицательный результат, даже при соблюдении всех правил сбора и транспортировки биологического материала.
Методы исследования
Процедура анализа проводится в несколько этапов:
- микроскопическая диагностика, позволяющая исследовать микроорганизмы под микроскопом;
- бактериологический диагностика — посев исследуемого материала на питательные среды (через шесть дней оценивается вид и активность микробов, регистрируется их количество);
- анализ восприимчивости кишечных микроорганизмов к антибиотикам.
Специалисты бактериологической лаборатории могут определить патогенных микроорганизмов, опираясь на их внешний вид, активность, наблюдаемую с помощью микроскопа. Этот метод называется бактериоскопическим исследованием.
Сроки выполнения
Для получения результата исследований требуется около недели. Этот срок не связан с организационными моментами, он необходим для обеспечения возможности максимального роста и последующего выявления возбудителей.
Для ускорения диагностики в некоторых диагностических лабораториях при анализе на кишечную группу применяют экспресс-методы. Но они зачастую имеют меньшую достоверность.
Расшифровка анализа
- присутствии патогенных бактерий (сальмонелл, шигелл, золотистого стафилококка, патогенных эшерихий, гемолизирующей кишечной палочки);
- активном росте колоний условно-патогенной микрофлоры (клебсиелл, серраций, синегнойных палочек, протей, цитро-бактерий).
В данном случае выдаются также результаты антибиотикограммы. Острый инфекционный период характеризуется резким нарушением состава кишечной микрофлоры — вытеснением нормальных микроорганизмов патогенными. Дефицит и отсутствие роста нормальных облигатных микробов косвенно может свидетельствовать о наличии кишечной инфекции, в таком случае специалисты рекомендуют сделать повторный анализ.
Положительный анализ, то есть выявление возбудителей дизентерии, сальмонеллезов или эшерихиозов при наличии клинической картины означает протекание данных заболеваний в острой форме. Отсутствие клинически значимых признаков свидетельствует о бессимптомном бактерионосительстве, в том числе, хроническом – в случае регулярных положительных результатах анализа. При получении сомнительного результата рекомендуется проведение повторного обследования. При отрицательных результатах анализа вероятность заболевания низка.
Что может влиять на результат?
Ложноотрицательные результаты может вызвать проводимая незадолго до анализа терапия антибиотиками либо химиотерапия.
Кто назначает обследования?
На анализ направляют врачи инфекционисты, терапевты, специалисты общей практики, педиатры и гастроэнтерологи.
Читайте также: